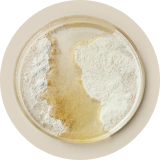

On a mission to create a world with more healthy, supported women.
Perelel is the first and only OB/GYN founded vitamin company—supporting women through every stage of life.
Discover the
Perelel Difference


By Doctors, For Doctors
I co-founded Perelel with one goal: To provide women with the support they need, when they need it. As an OB/GYN, I saw the reality of women’s vitamins firsthand—they took a “one-size-fits-all” approach, weren’t informed by research, and were filled with fillers and additives. More often than not, my patients were having to seek out specific dosages and ingredients based on their stage, sourcing vitamins from all over and sorting through bottles every morning.
With Perelel, we’ve created a suite of daily vitamins, supplements, and nutritional powders that are designed to give women the nutrients they need, no matter what stage they are in life. From conception through to birth, postpartum to perimenopause, we’ve built a system that truly supports women thoughtfully and safely.
Dr. Banafsheh Bayati,
MD, OB/GYN, FACOG Medical
co-Founder, Perelel
Founded and formulated by a world-class medical team.
Our Stage-Specific SolutionDoctor-made vitamins |
![]() Support |
![]() Prenatal |
![]() Prenatal |
![]() Prenatal |
![]() Support |
![]() Vitamin Trio |
![]() Support |
![]() Support |
![]() Support |
---|---|---|---|---|---|---|---|---|---|
For Who |
Women trying
|
Pregnant women
|
Pregnant women
|
Pregnant women |
Women in postpartum
|
For women of any age |
Men supporting general
|
Women freezing their eggs or |
Women supporting their body |
core prenatal |
|
|
|
|
|
|
|
|
|
Omega DHA + EPA |
|
|
|
|
|
|
|
|
|
stage specific vitamins |
CoQ10 to support |
B6 + Ginger for
|
Calcium + Magnesium to
|
Probiotic to support |
Ashwagandha and
|
Collagen and biotin supports |
CoQ10 may help support |
CoQ10 to support egg |
Ashwagandha to provide calm
|
Download Now | Download Now | Download Now | Download Now | Download Now | Download Now | Download Now | Download Now | Download Now |
Our Stage-Specific Solution
Doctor-made vitamins
for every stage of you.
for women who are
Women trying
to get pregnant
Pregnant women
during weeks 0 to 13
Pregnant women
during weeks 14 to 27
Pregnant women
during weeks 28+
Women in postpartum
or early motherhood
For women of any age
Men supporting general
and reproductive health
Women freezing their eggs or
beginning their IVF journey
Women supporting their body
through healing process after
any reproductive loss
core prenatal
omega dha epa
stage specific vitamins
CoQ10 to support
egg
health and ovulation*
B6 + Ginger for
anti-nausea support*
Calcium + Magnesium to
support skeletal growth*
Probiotic to support
maternal microbiome*
Ashwagandha and
L-theanine to support stress*
Collagen and biotin supports
healthy skin, hair and nails*
CoQ10 may help support
sperm motility and count*
CoQ10 to support egg
health and ovulation*
Ashwagandha to provide calm
and iron to replete stores*

Doctor-founded. Clinically-backed.
Every Perelel product is meticulously formulated with the help of the Perelel Panel. Together, we bridge published studies with the Panel’s clinical insights to land on a formula that honors the unique needs of each hormonal stage.
Clinically-Backed Ingredients

Clinical Trials

The Latest Research
The Practitioner Program
We’re proud to partner with medical professionals across the globe. Here’s how we’re showing up to support.
Questions? Please reach out to [email protected]
Your Cart (0)
Your cart is currently empty.
Shop By Stage

Planning for Pregnancy

1st Trimester: Weeks 0-13

2nd Trimester: Weeks 14-27

3rd Trimester: Weeks 28+

Postpartum

Motherhood

Supporting My Cycle

Daily Wellness

Men's Health

Personalize Your Routine
Take our 60-second quiz to determine the best products for your exact stage.
Take our quiz